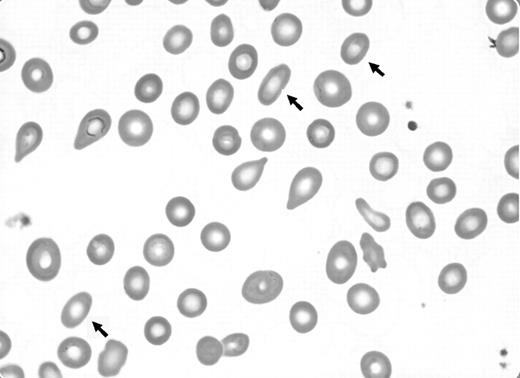
Figure 1. Arrows indicate stubby elliptocytes in Maslak's Blood Works image.

To the editor:
We wish to comment on the recent Blood Work image titled “Dacryocytes (teardrop cells).”1 The San Diego Hematopathology Club recently had a discussion of dacryocytes. It was pointed out by one of the senior members of the group that dacryocytes are invariably accompanied by an additional abnormal erythrocyte that is best characterized as a stubby elliptocyte. Further, in numerous published images of dacryocytes,2 (p 235), 3 (p 187), 4 (p 1300), 5 (p 566) at least one such cell is present but almost never mentioned. Dr Maslak's image1 supports this assertion (see arrows in Figure 1).
We informally tested the assertion that elliptocyte-like cells are a ubiquitous feature of leukoerythroblastosis. Peripheral blood films were evaluated from 30 archived cases with leukoerythroblastosis, predominantly from patients with primary myelofibrosis, for the presence of dacryocytes and stubby elliptocytes. The latter cell type, defined as an erythrocyte with 2 parallel membranes and a length to width ratio of between 1.5 and 2. 5 to 1, outnumbered dacryocytes on average more than 3 to 1. These cells were present in every examined peripheral blood film. As well, the relative proportions of stubby elliptocytes and dacryocytes remain relatively constant in cases as the leukoerythroblastic changes become more prominent.
The dacryocyte is appropriately recognized as the hallmark poikilocyte of leukoerythroblastosis. However, there is a dearth of references that have emphasized the constant presence of elliptocyte-like cells in this setting. This cell type certainly lacks the diagnostic specificity of dacryocytes, and stubby elliptocytes are present in other hematologic disorders. Stubby elliptocytes are present in iron deficiency, thalassemias, and other hereditary erythrocyte abnormalities, although they are not a dominant finding in these settings. Nevertheless, the identification of stubby elliptocytes, particularly in the clinical setting of suspected myeloproliferative disease, should prompt a diligent search for subtle but more definitive evidence of leukoerythroblastosis which has particular utility in the distinction between the cellular phase of primary myelofibrosis and essential thrombocythemia.
Naming this poikilocyte is problematic. Too short in the long axis for an elliptocyte and lacking the egglike contours of an ovalocyte, neither of these established terms seem appropriate without a modifier. The overlooked nature of this cell type suggests “never-noticed-that-before” cell or “wallflower” cell; however, these lack requisite descriptiveness. Stubocyte, while an economical chimera of stubby and elliptocyte, obtains ambiguity in that contraction. And, sadly, eponyms are out of favor.
The pathogenesis of both the stubby elliptocyte and the better-known dacryocyte is uncertain. Ultimately, the discovery of molecular mechanisms responsible for myeloproliferative disorders may also identify the cellular alterations that underlie the characteristic poikilocytes of myelofibrosis.
While it may not find a distinct place in the lexicon of poikilocytes, the stubby elliptocyte of leukoerythroblastosis is a valuable marker of myelophthisis and a reminder that in morphologic hematology, as in other arenas, we often only see what we are conditioned to expect.
Authorship
Conflict of interest disclosure: The authors declare no conflicting financial interests.
Correspondence: Michael Quigley, Laboratory Dept, 34800 Bob Wilson Dr, Naval Medical Center, San Diego, CA 92129; e-mail: mmquigley@nmcsd.med.navy.mil.
This feature is available to Subscribers Only
Sign In or Create an Account Close Modal